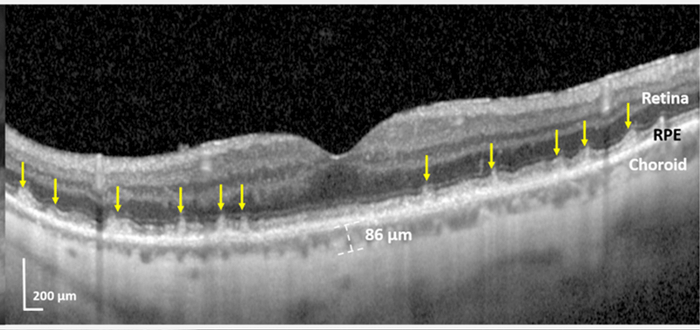
eye disease

(Photo by David Travis on Unsplash)
NEW YORK — A common eye disease that can result in blindness may be a warning sign of a future heart attack or stroke, a new study reveals.
Researchers from the Icahn School of Medicine at Mount Sinai in New York say people with a form of age-related macular degeneration (AMD) are more likely to develop cardiovascular disease. However, the discovery offers hope that doctors can create a screening program for heart problems.
“For the first time, we have been able to connect these specific high-risk cardiovascular diseases to a specific form of AMD, the one with subretinal drusenoid deposits (SDDs),” explains lead author R. Theodore Smith, MD, PhD, Professor of Ophthalmology at Mount Sinai, in a media release.
These deposits consist of fatty lipids that form beneath light sensitive retina cells at the back of the eye. As a result, they can lead to vision loss. Detection is difficult, requiring high-tech imaging scans.
“This study is the first strong link between the leading cause of blindness, AMD, and heart disease, the leading cause of death worldwide. Furthermore, we also have strong evidence for what actually happens: the blood supply to the eye is directly diminished by these diseases, either by heart damage that diminishes blood supply throughout the body, or from a blocked carotid artery that directly impedes blood flow to the eye,” Prof. Smith continues.
Vision loss can occur because of poor circulation resulting from heart disease. It can be a manifestation of an underlying vascular condition. The findings have important public health implications, opening the door to widescale screening — starting with someone’s eyes.
“A poor blood supply can cause damage to any part of the body, and with these specific diseases, the destroyed retina and leftover SDDs are that damage. Retinal damage means vision loss, and can lead to blindness,” Smith adds.
The study in the journal BMJ Open Ophthalmology is the first to identify high-risk cardiovascular diseases linked to the eye disorder. AMD is the leading cause of blindness in people over 65. It results from damage to the central area of the retina, called the macula, which is responsible for reading and driving vision.
SDDs contain cholesterol and form above a part of the retina called the retinal pigment epithelium (RPE). Currently, there is no known treatment for SDDs. An analysis of 200 AMD patients with severe cardiovascular diseases and stroke found they were nine times more likely to have SDDs.
“This work demonstrates the fact that ophthalmologists may be the first physicians to detect systemic disease, especially in asymptomatic patients,” says co-investigator Richard Rosen, MD, Chief of the Retina Service for the Mount Sinai Health System.
“Detecting SDDs in the retina should trigger a referral to the individual’s primary care provider, especially if no previous cardiologist has been involved. It could prevent a life-threatening cardiac event.”
Estimates show that nearly 20 million Americans are living with some form of age-related macular degeneration. Meanwhile, cardiovascular disease is the number one killer worldwide.
“This study has opened the door to further productive multidisciplinary collaboration between the Ophthalmology, Cardiology and Neurology services,” says Jagat Narula, MD, PhD, Director of the Cardiovascular Imaging Program at the Zena and Michael A. Wiener Cardiovascular Institute at the Icahn School of Medicine at Mount Sinai.
“We should also focus on defining the disease severity by vascular imaging in cardiology and neurology clinics, and assess their impact on AMD and SDDs with retinal imaging. In this way we can learn which vascular patients should be referred for detection and prevention of blinding disease.”
South West News Service writer Mark Waghorn contributed to this report.







